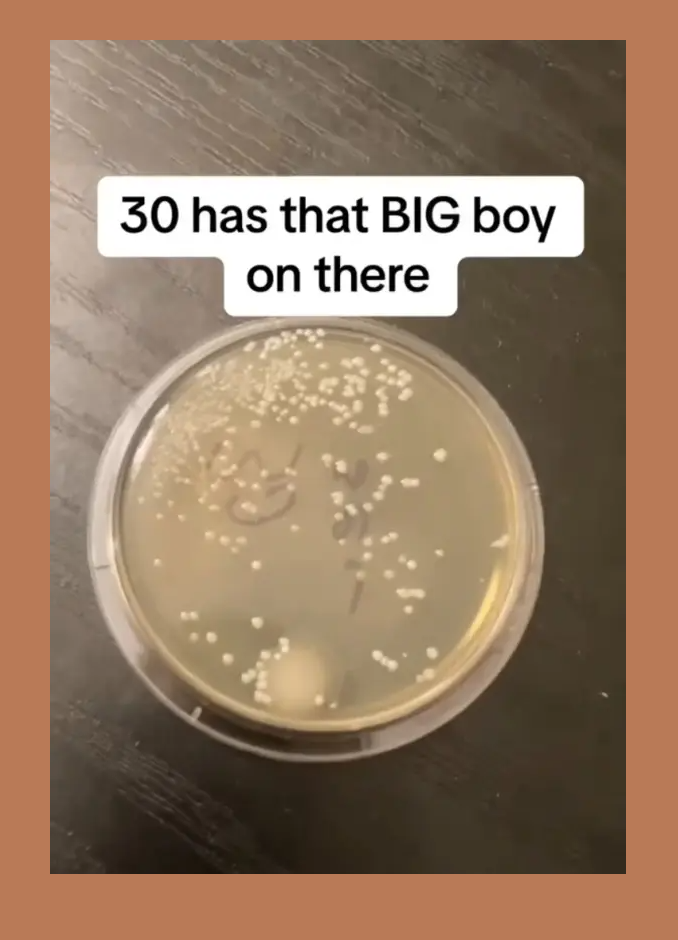

Все быстро подбирают еду, чтобы предотвратить заражение — но является ли этот метод проверенным и верным или это просто бабушкины сказки? Чикагский микробиолог проверил так называемое «правило пяти секунд», чтобы научно оценить, безопасно ли есть еду, упавшую на пол, как показано в клипе TikTok, набравшем более 1 миллиона просмотров.
«Я подумал, что людям будет забавно узнать обо всех тех маленьких гадостях, о которых мы не задумываемся каждый день», — рассказал изданию Jam Press Николас Айхер, старший аналитик по контролю качества.
Исследователь собрал почти 450 000 подписчиков на своем канале TikTok , куда он загружает видеоролики, в которых он проверяет чистоту повседневных предметов — от бензоколонок до зубных щеток и даже полости рта собаки.
@howdirtyis
Для своего последнего гигиенического эксперимента Айхер решил поставить чашку Петри на землю на разные промежутки времени — от нуля секунд до одной минуты.
Затем он инкубировал образцы в культиваторе, чтобы увидеть, в какой степени они давали бактериальные плоды.
Как оказалось, в каждом образце имелись признаки роста микроорганизмов, что доказывает, что никакое время нахождения на полу не является безопасным с точки зрения заражения.
«Похоже, даже 0 секунд — это слишком долго», — заявил ученый, держа в руках соответствующую чашку Петри, усеянную белыми бактериальными пятнами.

@howdirtyis
По совпадению, пятисекундная выборка показала примерно такой же рост, что фактически опровергает правило.
В какой-то момент Айхер случайно роняет это блюдо, переставляя его, и на столе остается некрасивое белое пятно.
Между тем, в чашке, оставленной на 10 секунд, было «немного больше» бактерий, тогда как в чашках, оставленных на 20 и 30 секунд, их было заметно больше.
Интересно, что образец, оставленный на одну минуту, имел такое же количество, что и пятисекундный.
На основании этих результатов Айхер пришел к выводу, что независимо от того, оставлена ли еда на «пять секунд или на 60, она в любом случае будет неприятной».
@howdirtyis Replying to @alwayssimply1024 Is there any truth to the 5 second rule? #science #germ #sciencebiatch #gross #nasty #howdirtyis #dirty #interesting #bacteria #sciencetok #cool #fyp #clean #foryou #micro #curious #サイエンス #科学 #実験 #バクテリア #funfact #facts #fact #germs #interestingfact #interestingfacts #amazingfact #amazingfacts #amazing #randomfacts #randomfact #randomfactsforyou #factstime #dailyfact #funfacts #factoftheday #funfactoftheday #bio #biology #biomed #lab #labwork #cleantok#laboratorio #biologia #microbiologia #scitok #ScienceTok #scienceismagic #scienceiscool #sciencefair #foreigngerms #germsquad #mygerms #viral #bacterial #bacterialcontamination #petriedish #実験 #面白い #面白い動画 #viral #viralvideo #viraltiktok #trending w#trendingvideo #trendingtiktok #세균 #stem #stem #stemfeed #STEMfeed #longervideos #과학 #과학실험 #실험 #박테리아 #웃긴영상 #재미있는영상#scienceexperiment #scienceexperiments #experiment #learnontiktoktogether ♬ Stylish Jazz HipHop – Future Oriented Triad
Зрители были возмущены результатами, а один из них написал: «Никогда больше не буду есть еду с пола».
«Неееет, я ЖИВУ по правилу пяти секунд!» — написал другой, а третий съязвил, что микробы придают «дополнительный вкус».
Несмотря на шокирующие результаты, многие приверженцы правила пяти секунд отказались отказаться от употребления в пищу еды с земли.
«Я сделаю вид, что не видел этого, чтобы продолжить с удовольствием следовать правилу пяти секунд», — заявил один упрямый фанат.
«Реальный фактор — это то, насколько сильно вы не хотите тратить то, что выронили», — заметил другой.
Один скептик усмехнулся: «Ну и ну. Я все детство следовал правилу пяти секунд и до сих пор здоров».
Однако другие посчитали, что результаты были испорчены тем фактом, что у Айхера не было «контрольного» образца, который подвергался воздействию только воздуха.
